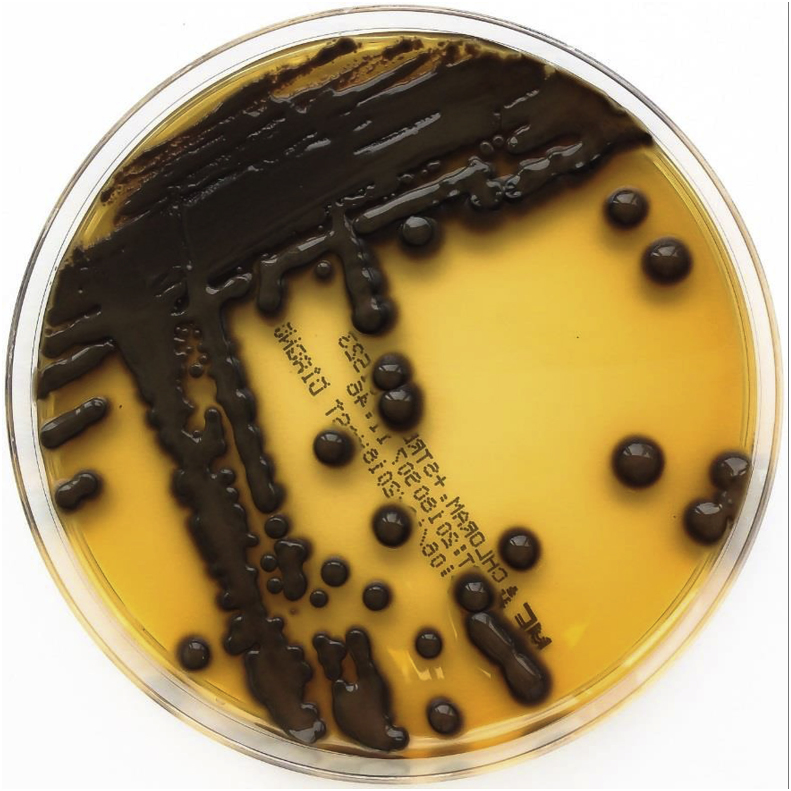
Fig. 2
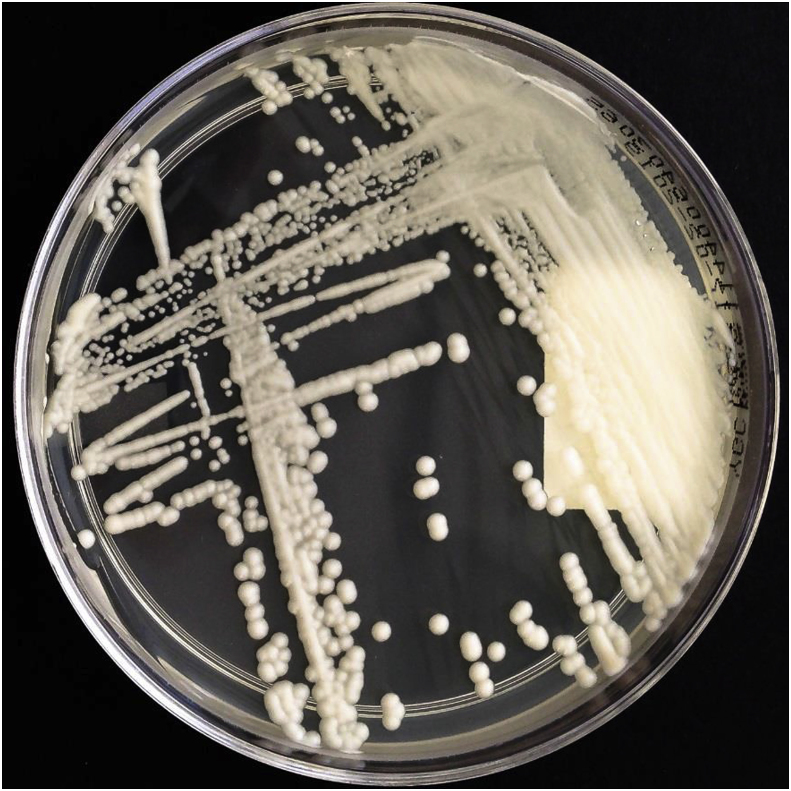
Fig. 3
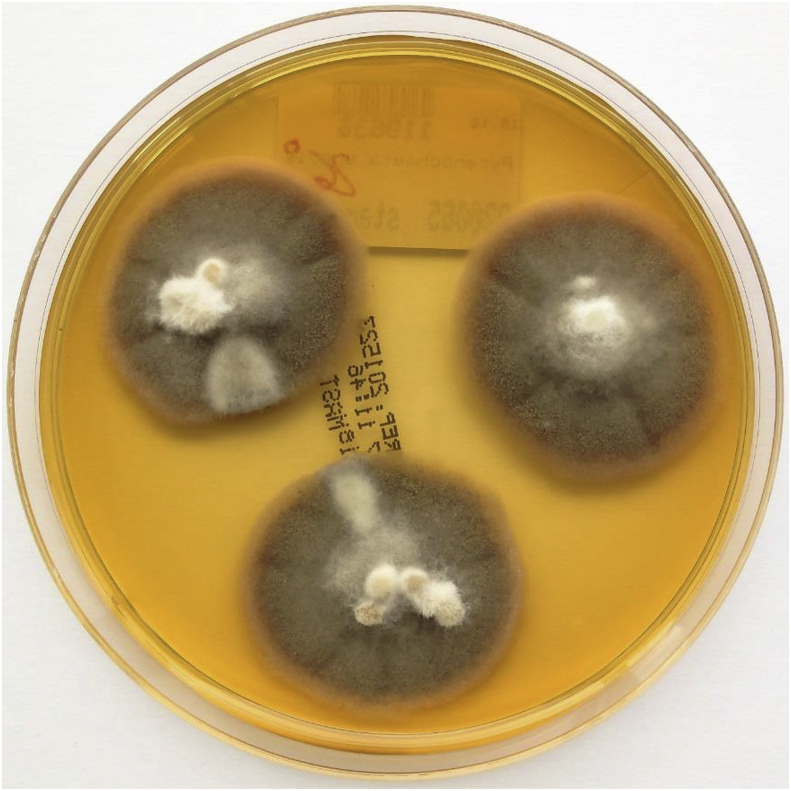
Fig. 4
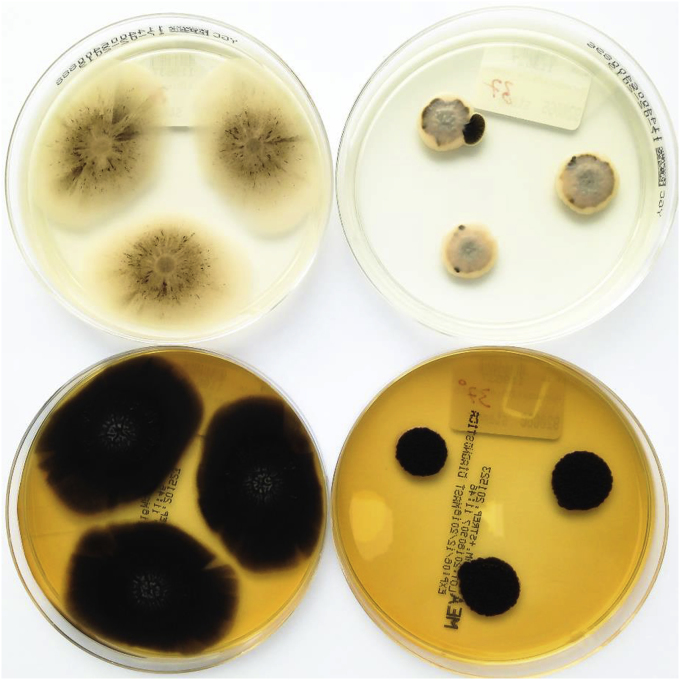
Fig. 6

Abstract
Here we present a 79-year old man with chronic hypersensitivity pneumonitis probably caused by fungal contamination of a bagpipe. Several samples were taken from the patient's bagpipe. Four potential fungal antigens (Exophiala phaeomuriformis, Kwoniella europaea, Pyrenochaeta unguis-hominis and Aureobasidium melanogenum) as potential trigger of hypersensitivity pneumonitis were identified. A serum ELISA test with Exophiala phaeomuriformis indicated reactivity.
Cessation of playing the bagpipe and application of glucocorticoids lead to an improvement of the patient's symptoms.
Keywords: Hypersensitivity pneumonitis, Bagpipe, Fungal antigens, Serological testing
1. Introduction
Hypersensitivity pneumonitis (HP) is an interstitial lung disease caused by an immuno-allergic reaction following the inhalation of a trigger noxa to which the patient has been sensitized before [1]. There are many bacterial, fungal, plantal and chemical antigens previously discovered to cause HP [2,3]. Nevertheless, in up to 50% of the patients with proven HP, no offending antigen can be identified [4]. Not recognizing the causative antigen, leads to maintenance of continuous exposure and might lead to disease progression and shorter survival [5]. Consequently, finding the trigger agent followed by avoidance of it, is the principal treatment of HP [6].
We report the first case of HP in a bagpipe player presumably caused by contamination of the bagpipe with the fungal organisms Exophiala phaeomuriformis, Pyrenochaeta unguis-hominis, Kwoniella europaea and Aureobasidium melanogenum.
2. Case
A 79 - year old man presented to the pneumology outpatient department on 25/05/2018 (day 0) with a six months' history of exertional dyspnea and weight loss of seven kilograms. His medical history revealed no previous pulmonary or autoimmune disease. During his life he was a nonsmoker and worked in the office. The patient was playing the bagpipe for 20 years. Physical examination yields in the auscultation of the lungs crackles. Apart from that, there were no abnormal results in physical examination. The six - minute walk distance was slightly reduced with 398 m. Oxygen saturation at rest was 97% with no dyspnea, after walking exercise significant drop of oxygen saturation to 91%, dyspnea of 3 on the Borg scale (range 0–10) and no muscular exhaustion. The lung function test showed a moderate restrictive respiratory disorder: total lung capacity 4.18 L, 59% predicted, vital capacity 2.26 L, 57% predicted, FEV1 1.95 L, 68% and residual volume 1.92 L, predicted 68%. Transthoracic echocardiography and ECG were inconspicuous. A bronchoscopy with bronchoalveolar lavage was performed. Cytology of the bronchoalveolar lavage fluid (BALF) showed no malignant cells, a lymphocytosis of 17% was found with a CD4/CD8 quotient of 1:2.5 (normal: 0.7–2.8) and CD56-NK cells of 12.1% (normal: 5–29%). Microbiological examination of the BALF revealed no evidence of fungal growth, mycobacteria or disease-causing bacteria. Blood gas analysis breathing ambient air revealed the following results: pH = 7.41, pCO2 = 37.6 mmHg, pO2 = 67.5 mmHg, TLCO 23%, demonstrating a severe disorder of gas exchange. There were no abnormal results in other blood analyses. These examinations were performed on day 0–4.
An externally performed computed tomography of the thorax (day – 49) showed subpleural reticular bronchiectasis (DD fibrotic changes) and mosaic perfusion with nodular densities in the right upper lobe. A HRCT follow-up scan from 06/08/2018 (day 73) of the thorax demonstrated regressive interstitial infiltrates bipulmonal, regressive ground glass opacities predominating in the right middle-lobe and unchanged markedly subpleural fibrotic changes on both lung fields (Fig. 1).
Fig. 1.
HRCT-Scan of the patient from August 2018.
Several samples were taken from the patient's bagpipe (day 26), including the mouthpiece, pipe, bag, chanter and drone and were examined for microbiological growth including mycobacteria. All cultures were negative for mycobacteria. Bacterial and mycologic sampling revealed a colonization of the bagpipe with coagulase-negative staphylococci, Kocuria species, Bacillus pumilus, Pseudomonas oryzihabitans, Rhodoturula mucilaginosa, Exophiala phaeomuriformis (Fig. 2), Kwoniella europaea (Fig. 3) Pyrenochaeta unguis-hominis (Fig. 4, Fig. 5), and Aureobasidium melanogenum (Fig. 6). Identification of bacteria and fungi was performed by MALDI-TOF MS and morphological examination together with sequencing the internal transcribed spacer region of the rDNA of the fungi as previously described [7].
Fig. 2.
Exophiala phaeomuriformis on malt extract agar after 14 days at 26 °C incubation.
Fig. 3.
Kwoniella europaea on YGC-agar after 5 days at 35 °C incubation.
Fig. 4.
Pyrenochaeta unguis-hominis on malt extract agar after 14 days at 26 °C incubation.
Fig. 5.
Pyrenochaeta unguis-hominis Lactophenol stain 400× magnification.
Fig. 6.
Aureobasidium melanogenum on YGC (top) and malt extract (bottom) agar after 14 days at 26 °C (left) and 37 °C (right) incubation.
To analyze if there are responsible trigger antigens, the following noxa were tested: Serum-IgG-antibodies against common HP-antigens (pigeon serum/feather/feces, budgerigar serum/feather/feces, Saccharopolyspora rectivirgula, Thermoactinomyces vulgaris, Aspergillus fumigatus, Penicillium chrysogenum, Pseudomonas fluorescens, Aureobasidium pullulans and Cephalosporium acremonium) were all in the normal range (day 4). In addition, Ouchterlony-diffusion-test was done with Pyrenochaeta unguis-hominis, Exophiala phaeomuriformis and Kwoniella europaea which showed no precipitation lines. The Ouchterlony-test is known to have a lower sensitivity than the ELISA in detecting a trigger antigen. Therefore, we did in addition an ELISA test with Exophiala phaeomuriformis as previously described [8]. The specific IgG of the patient's serum against Exophiala phaeomuriformis detected by measuring the extinction, was higher than 85% of a control group with 21 healthy individuals.
In the interdisciplinary lung fibrose board (day 12) in consideration of the examinations, laboratory and microbiological markers, the most likely cause of the patient's problem was seen in an interstitial lung disease due to chronic HP caused by playing the bagpipe for 20 years. The patient was recommended ceasing to play the instrument immediately (day 5). He obtained 30 mg prednisolone (approximately day 27) daily for four weeks. Gradual dose reduction to 10 mg was recommended. Cessation of playing the bagpipe and application of glucocorticoids lead to an improvement of the patient's symptoms as reported on day 249.
3. Discussion
Considering the portrayed patient's medical history, examinations and further course, the most likely diagnosis of the patient was chronic HP.
Our patient presented clinically weight loss and inspiratory crackles, a restrictive pattern in the pulmonary function test and ground glass opacities together with fibrotic changes in the HRCT scan. These findings are not specific for HP but include HP as an important differential diagnosis. Further the examination of the patient's bagpipe revealed a contamination with several fungi as mentioned above. Contamination of wind instruments with fungi [9] and cases of HP triggered by fungi, colonizing musical instruments, were described before [10,11] but still rarely reported. With this article four potential fungal trigger of HP in a bagpipe player are described: Exophiala phaeomuriformis, Pyrenochaeta unguis-hominis, Kwoniella europaea and Aureobasidium melanogenum. These fungi are known for causing different mycosis [[12], [13], [14]]. Exophiala phaeomuriformis belongs to the order of Chaetothyriales [12] and to the dematiaceous fungi. It has been isolated rarely, from lung or pleural fluid, blood, heart, bone marrow, breast, paranasal sinus and nail [12]. In addition, it was reported to cause fungal keratitis [13]. Pyrenochaeta unguis-hominis belongs to the form-class of the Coelomycetes and to the order of Pleosporales. It was described in causing infection of the finger-nail [15]. Kwoniella europaea has not been reported in human disease yet. Aureobasidium melanogenum belongs to the order of Dothideales. Aureobasidium pullulans and Aureobasidium species were already mentioned as causative agents of HP [[1], [2], [3]].
The bacteria and fungi were cultured and used in an Ouchterlony test, which could not detect serum precipitating antibodies. Therefore, an ELISA-test was performed with one of these germs (Exophiala phaeomuriformis). The measured extinction of the patient serum was higher than 85% of a control group with 21 healthy individuals. Usually as cut-off at least the 95% quartile is taken, so the result would be interpreted as negative. A recent multicenter study establishing reference values for IgG-antibodies measured in the ImmunoCAP-system showed, that for some antigens the reference values varied considerably in comparison to preceding studies and a cut-off above the 95% quartile could not be optimal for all antigens [16]. Nevertheless, other criteria of a HP are fulfilled, so the diagnosis is highly probable. Reasons for a seronegative HP could be inadequate IgG-production in an individual, or testing the wrong antigens. It's possible, that ELISA tests with Pyrenochaeta unguis-hominis and Kwoniella europaea would have been positive, but they could not be done due to logistic problems.
Lacasse et al. presented six significant predictors of HP [17]: exposure to a known offending antigen, positive precipitating antibodies, recurrent episodes of symptoms, inspiratory crackles, symptoms 4–8 h after exposure and weight loss [17]. The probability of having HP increases with the accomplishment of each single predictor [17].
According to the review of Soumagne et al. [1], five major criteria were recommended to propose the diagnosis of HP, of which the first four are mandatory:
-
1)
Compatible respiratory symptoms.
-
2)
Evidence of antigenic exposure: retained either by the history-taking, or by the presence of precipitins, or possibly by samples of the antigenic source.
-
3)
Lymphocyte alveolitis in bronchoalveolar lavage fluids.
-
4)
Decrease of lung transfer for carbon monoxide (TLCO) or hypoxia or exercise desaturation.
-
5)
Compatible imaging (standard chest radiography or HRCT).
In our case only criteria number 3) was not fulfilled.
In the literature only few reports of HP due to contaminated musical instruments exist [10,11,18]. There is one described bagpipe lung case [10]. In contrary to our patient, in that case the bagpipe contamination was not recognized as trigger of HP during the patient's life [10]. Serum-precipitating antibodies were not performed [10]. Fungal cultures of the bagpipe were taken shortly before the patient died [10].
The purpose of this case report is to call attention to the fact that patients with suspected HP might be exposed to a fungal antigen that is not reported in literature but still can be approached by isolating the antigen and subsequently testing for serum-specific antibodies. The benefit for the patient is having the opportunity of avoiding the offending antigen which is the only causal and main treatment of HP [6].
Conflict of interest
All authors declare no conflict of interest.
Acknowledgements
We thank M. Schmidt for taking the pictures of the fungi and T. Schrauzer for the interpretation of the HRCT scan.
References
- 1.Soumagne T., Dalphin J.C. Current and emerging techniques for the diagnosis of hypersensitivity pneumonitis. Expert Rev. Respir. Med. 2018 Jun;12(6):493–507. doi: 10.1080/17476348.2018.1473036. [DOI] [PubMed] [Google Scholar]
- 2.Nogueira R., Melo N., Novais E Bastos H., Martins N., Delgado L., Morais A. Hypersensitivity pneumonitis: antigen diversity and disease implications. Pulmonology. 2018 Aug 17 doi: 10.1016/j.pulmoe.2018.07.003. pii: S2531-0437(18)30112-0. [DOI] [PubMed] [Google Scholar]
- 3.Riario Sforza G.G., Marinou A. Hypersensitivity pneumonitis: a complex lung disease. Clin. Mol. Allergy. 2017 Mar 7;15:6. doi: 10.1186/s12948-017-0062-7. [DOI] [PMC free article] [PubMed] [Google Scholar]
- 4.Elicker B.M., Jones K.D., Henry T.S., Collard H.R. Multidisciplinary approach to hypersensitivity pneumonitis. J. Thorac. Imaging. 2016 Mar;31(2):92–103. doi: 10.1097/RTI.0000000000000186. [DOI] [PubMed] [Google Scholar]
- 5.Fernandez Perez E.R., Swigris J.J., Forssen A.V., Tourin O., Solomon J.J., Huie T.J. Identifying an inciting antigen is associated with improved survival in patients with chronic hypersensitivity pneumonitis. Chest. 2013 Nov;144(5):1644–1651. doi: 10.1378/chest.12-2685. [DOI] [PMC free article] [PubMed] [Google Scholar]
- 6.Girard M., Lacasse Y., Cormier Y. Hypersensitivity pneumonitis. Allergy. 2009 Mar;64(3):322–334. doi: 10.1111/j.1398-9995.2009.01949.x. [DOI] [PubMed] [Google Scholar]
- 7.Steinmann J., Schmidt D., Buer J., Rath P.M. Discrimination of Scedosporium prolificans against Pseudallescheria boydii and Scedosporium apiospermum by semiautomated repetitive sequence-based PCR. Med. Mycol. 2011 Jul;49(5):475–483. doi: 10.3109/13693786.2010.539630. [DOI] [PubMed] [Google Scholar]
- 8.Sennekamp J., Koschel D., aufm Kampe A., Hermanns M., Huber M., Meyer zu Schwabedissen H. Serumdiagnostik der Zimmerspringbrunnen-alveolitis. Atemw.- Lungenkrkh. 2005 Apr;31:182–187. [Google Scholar]
- 9.Soumagne T., Reboux G., Metzger F., Roussel S., Lefebvre A., Penven E. Fungal contamination of wind instruments: immunological and clinical consequences for musicians. Sci. Total Environ. 2019 Jan 1;646:727–734. doi: 10.1016/j.scitotenv.2018.07.284. [DOI] [PubMed] [Google Scholar]
- 10.King J., Richardson M., Quinn A.M., Holme J., Chaudhuri N. Bagpipe lung; a new type of interstitial lung disease? Thorax. 2017 Apr;72(4):380–382. doi: 10.1136/thoraxjnl-2016-208751. [DOI] [PubMed] [Google Scholar]
- 11.Metzger F., Haccuria A., Reboux G., Nolard N., Dalphin J.C., De Vuyst P. Hypersensitivity pneumonitis due to molds in a saxophone player. Chest. 2010 Sep;138(3):724–726. doi: 10.1378/chest.09-2991. [DOI] [PubMed] [Google Scholar]
- 12.Zeng J.S., Sutton D.A., Fothergill A.W., Rinaldi M.G., Harrak M.J., de Hoog G.S. Spectrum of clinically relevant Exophiala species in the United States. J. Clin. Microbiol. 2007 Nov;45(11):3713–3720. doi: 10.1128/JCM.02012-06. [DOI] [PMC free article] [PubMed] [Google Scholar]
- 13.Aggarwal S., Yamaguchi T., Dana R., Hamrah P. Exophiala phaeomuriformis fungal keratitis: case report and in vivo confocal microscopy findings. Eye Contact Lens. 2017 Mar;43(2):e4–e6. doi: 10.1097/ICL.0000000000000193. [DOI] [PubMed] [Google Scholar]
- 14.Machen L., Chau F.Y., de la Cruz J., Sugar J., Cortina M.S. Recognition of fungal keratitis in boston type I keratoprosthesis: importance of awareness and novel identification of Exophiala phaeomuriformis. Cornea. 2018 May;37(5):655–657. doi: 10.1097/ICO.0000000000001541. [DOI] [PubMed] [Google Scholar]
- 15.English M.P. Infection of the finger-nail by Pyrenochaeta unguis-hominis. Br. J. Dermatol. 1980;103:91. doi: 10.1111/j.1365-2133.1980.tb15843.x. [DOI] [PubMed] [Google Scholar]
- 16.Raulf M., Joest M., Sander I., Hoffmeyer F., Nowak D., Ochmann U. Referenzwerte für die IgG-Bestimmung gegen typische Allergene der exogen allergischen Alveolitis-aktuelle Daten einer Multizenter-Studie. AJI. 2017;26:39. [Google Scholar]
- 17.Lacasse Y., Selman M., Costabel U., Dalphin J.C., Ando M., Morell F. Clinical diagnosis of hypersensitivity pneumonitis. Am. J. Respir. Crit. Care Med. 2003 Oct 15;168(8):952–958. doi: 10.1164/rccm.200301-137OC. [DOI] [PubMed] [Google Scholar]
- 18.Metersky M.L., Bean S.B., Meyer J.D., Mutambudzi M., Brown-Elliot B.A., Wechsler M.E. Trombone player's lung: a probable new cause of hypersensitivity pneumonitis. Chest. 2010 Sep;138(3):754–756. doi: 10.1378/chest.10-0374. [DOI] [PubMed] [Google Scholar]